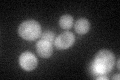
YGR205W
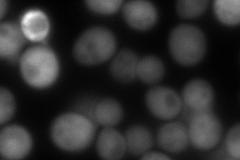
YGR205W
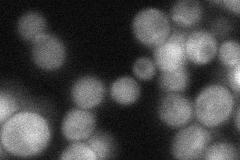
YGR205W
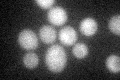
YGR205W

View description
ATP-binding protein of unknown function; crystal structure resembles that of E.coli pantothenate kinase and other small kinases
Localization:
Intensity:
Fold change:
Significance:
-
C’ GFP library in SD
cytosol32.97 -
N' NOP1pr-GFP in SD

cytosol168.585 -
N' TEF2pr-mCherry in SD
cytosol239.733 -
N' NATIVEpr-GFP in SD
cytosol34.7269 -
N' TEF2pr-VC and Cyto-VN in SD

#N/A0 -
C’ GFP library in SD+DTT

cytosol35.381.07No -
C’ GFP library in SD+H2O2
cytosol37.11.12No -
C’ GFP library in Starvation Media

cytosol46.051.39No -
C’ GFP library on the background of Pup2-DaMP

cytosol -
C’ GFP library on the background of CCT mutant

cytosol31.54290.956498No
